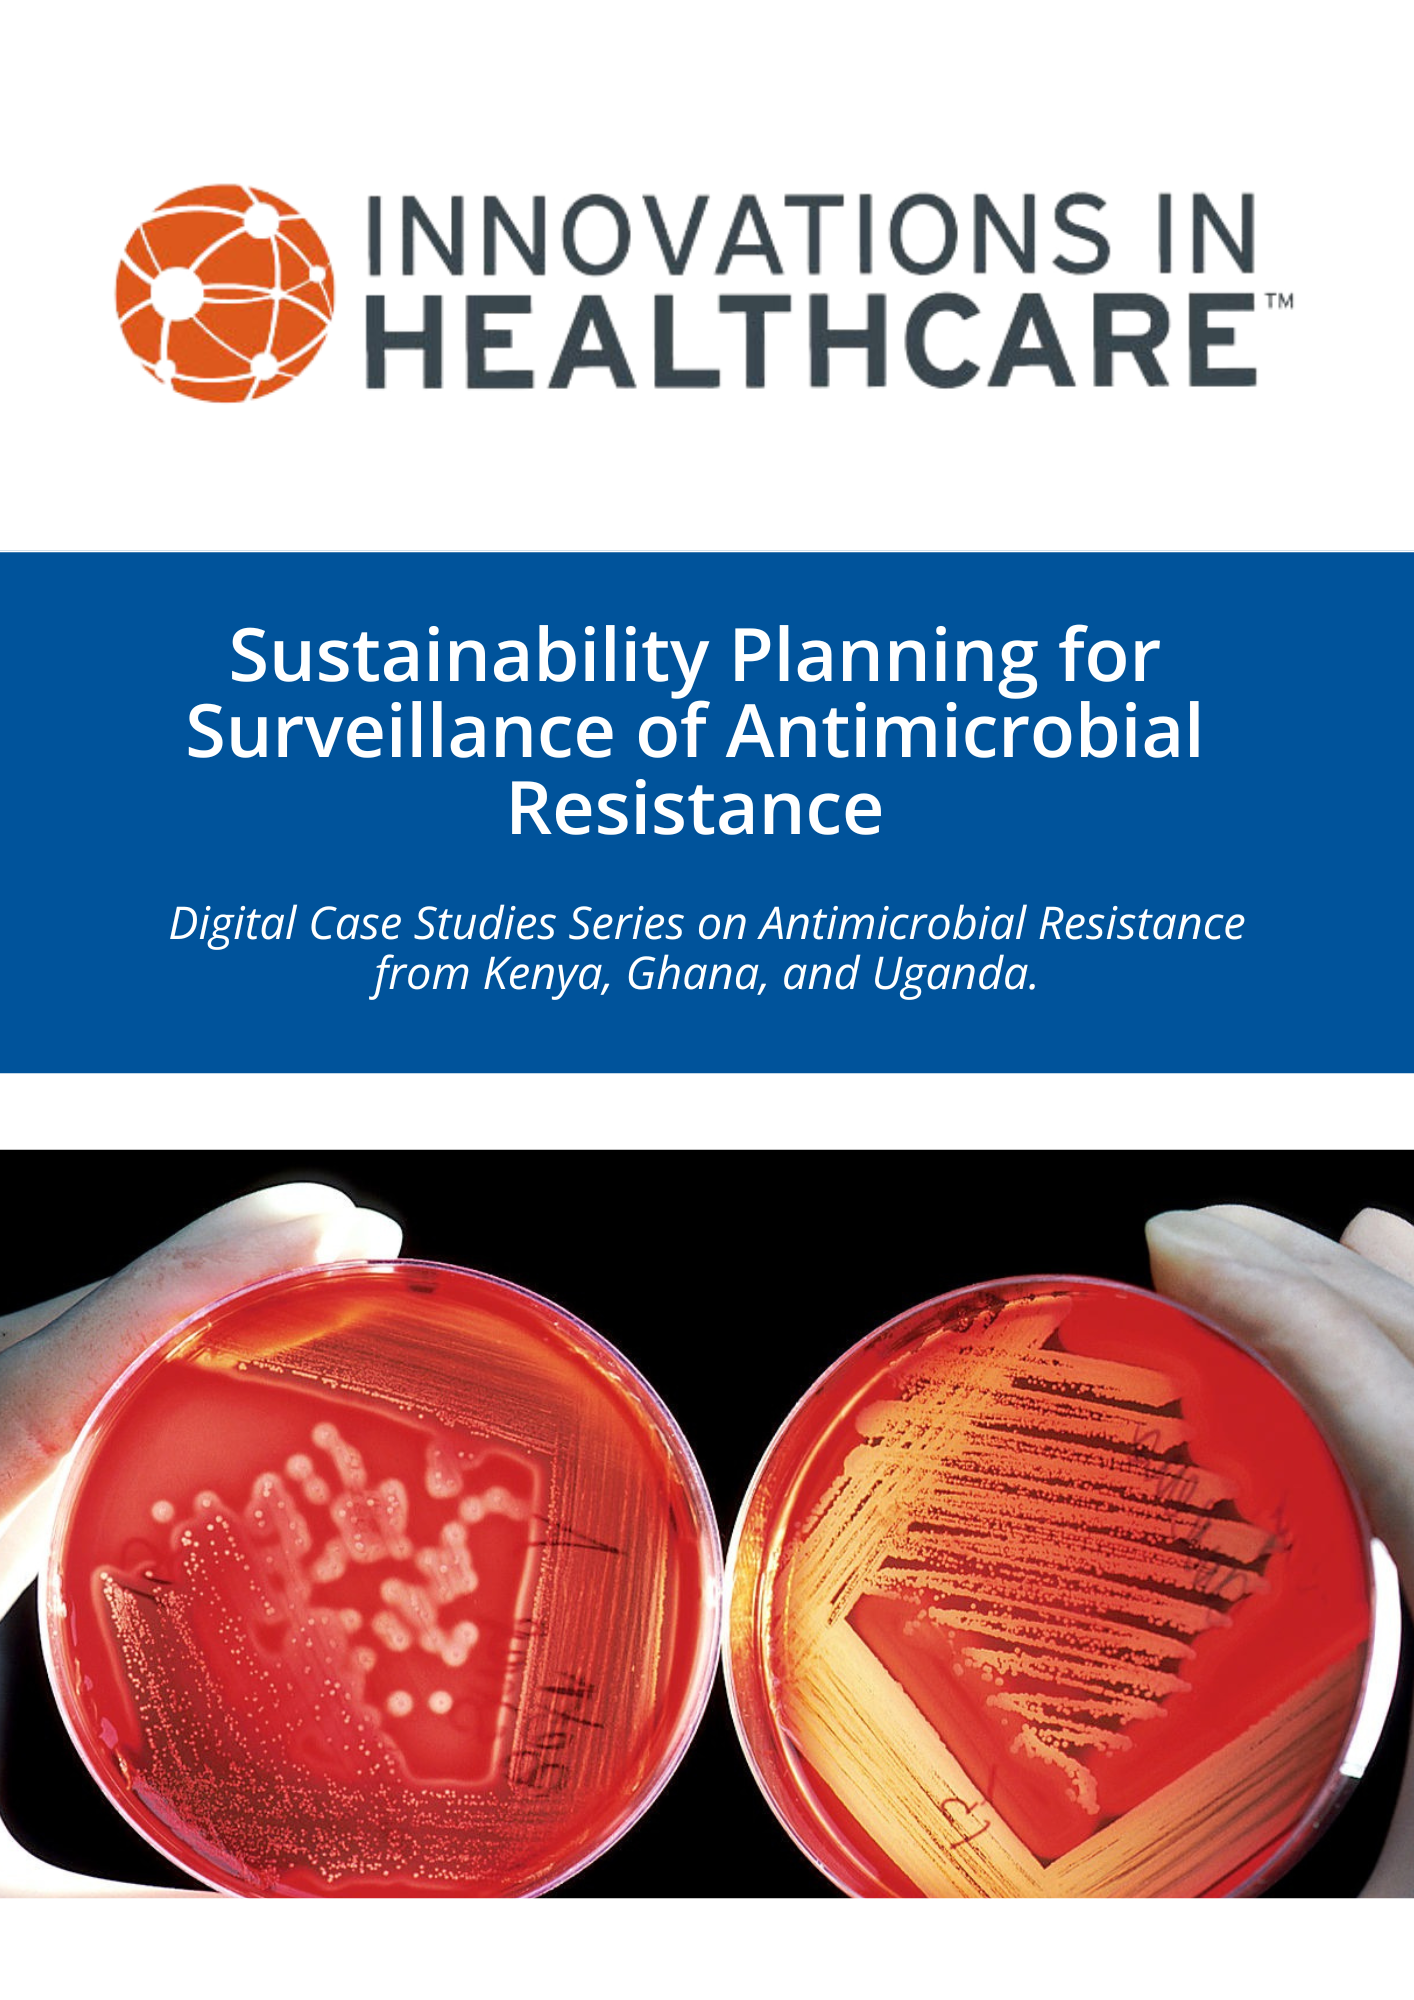

via Innovations in Healthcare.
Antimicrobial resistance (AMR) is a significant global public health menace. The highest mortality rates are seen in Sub-Saharan Africa, where there is a significant shortage of trained professionals and microbiology laboratories for antimicrobial susceptibility testing.
To address this, Pfizer Inc., Wellcome Trust, and the Ministries of Health in Ghana, Kenya, Malawi, and Uganda initiated the Surveillance Partnership to Improve Data for Action on AMR (SPIDAAR), a pilot public-private partnership. SPIDAAR aimed to enhance AMR surveillance by training staff in eight hospitals across four countries to conduct diagnostics on 100 isolates per site for five leading pathogens. The isolates were sent to the National Institute for Communicable Diseases (NICD) in South Africa for confirmation, facilitating trend analysis and feedback on culture accuracy.
In May 2021, Pfizer engaged Innovations in Healthcare (IiH) to support the sustainability of SPIDAAR beyond its pilot phase. IiH provided resources, guidance, and a sustainability framework, and developed a checklist and assessment tool to help AMR teams monitor progress. IiH also organized peer learning sessions to address common challenges.
IiH developed each case study through desk review and in-depth interviews conducted with team members from selected hospitals and Ministry of Health. The case studies highlight how AMR surveillance is implemented in each context through SPIDAAR, challenges faced in implementation, and a brief description of how they addressed challenges or observed improvement, where such information is available. The experiences documented will inform Ministries of Health, development partners, and health facility leadership and administrators interested in strengthening the capacity of facilities and national AMR teams to sustain AMR surveillance.
